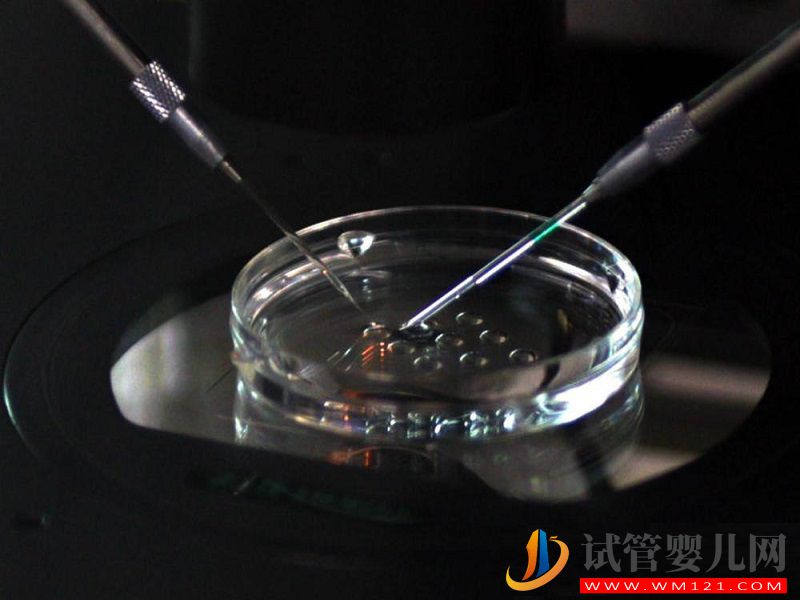
揭秘二代試管全過程，其實就是檢查、進周兩大階段(圖6)

?
91精品国产色综合久久|
欧美一区二区三区……|
国产同性人妖ts口直男|
欧美先锋影音|
99热在线播放|
菠萝蜜视频网站入口|
国产清纯在线一区二区www|
天天色综合天天色|
rebdb初裸写真在线观看|
亚洲精品之草原avav久久|
超碰在线97观看|
亚洲狼人精品一区二区三区|
奇米精品在线|
91热爆在线观看|
一本在线高清不卡dvd|
成年人免费视频播放|
婷婷精品在线观看|
成人久久久久爱|
www.香蕉视频在线观看|
亚洲黄色av一区|
天天躁日日躁aaaxxⅹ|
成人台湾亚洲精品一区二区|
国产91精品网站|
樱花草在线观看www|
国产精品乱人伦|
艳妇乳肉豪妇荡乳xxx|
涩爱av色老久久精品偷偷鲁|
国产福利成人在线|
奇米影视四色在观看线|
亚洲欧美精品午睡沙发|
国产美女精品久久|
亚洲成a人片77777在线播放|
92看片淫黄大片欧美看国产片
|
国产精品久久久久久久久男|
九九夜夜操妹子|
亚洲综合免费观看高清在线观看|
30一40一50老女人毛片|
日本午夜精品|
91九色国产社区在线观看|
国产经典av|
色综合久久66|
黄色激情视频在线观看|
亚洲福利专区|
99精品一区二区三区的区别|
黄色小网站在线观看|
亚洲深夜福利在线|
视频污在线观看|
91在线视频网址|
欧美高清精品一区二区|
深夜福利一区|
91午夜理伦私人影院|
www 四虎|
欧美日韩精品一区二区三区四区|
99超碰在线观看|
日韩经典中文字幕一区|
黄色动漫在线免费看|
欧美片第一页|
91a在线视频|
好看的黄色网址|
欧美色videos|
国产欧美一区二区三区在线看蜜臂|
亚洲影院免费|
国产精品333|
国产精品字幕|
国产精品爱啪在线线免费观看|
av色资源站|
91久久精品日日躁夜夜躁欧美|
日本三级免费看|
久久视频一区|
国产a级片免费观看|
日韩电影免费观看高清完整版在线观看|
国产91色在线|免|
av福利在线观看|
欧美日韩另类一区|
伊人网站在线观看|
国产suv精品一区二区6|
无码人妻一区二区三区精品视频|
久久夜色电影|
久久综合福利|
国产黄色在线网站|
欧美国产精品日韩|
美女污污网站|
欧美在线综合视频|
艳妇乳肉豪妇荡乳av|
av欧美精品.com|
中文文字幕文字幕高清|
欧美高清视频手机在在线|
一区二区三区四区欧美|
都市激情国产精品|
日韩av色在线|
91久久影院|
日韩精品在线观看一区|
亚洲欧美日韩成人网|
亚洲夂夂婷婷色拍ww47|
日本三级理论片|
久久成人麻豆午夜电影|
亚洲国产欧美日韩在线|
av在线不卡免费观看|
在线观看成人av电影|
色在线视频观看|
国产精品久久久久久久av大片|
中文字幕av网|
亚洲欧美另类自拍|
国产精品作爱|
在线欧美日韩精品|
精品国产无码AV|
国产精品青草久久|
九九热精彩视频|
免费久久精品视频|
特级特黄刘亦菲aaa级|
国产精品成人一区二区不卡|
国产一级不卡视频|
99综合久久|
国产在线一区二区三区欧美|
最新国产露脸在线观看|
日本一区二区在线播放|
中文字幕国产在线|
中文字幕亚洲一区二区三区五十路|
午夜免费入口|
欧美一级一区二区|
中文字幕欧美日韩久久|
狠狠久久亚洲欧美专区|
av在线资源观看|
136国产福利精品导航|
日产精品久久久|
99在线精品一区二区三区|
国产大屁股喷水视频在线观看|
久久永久免费|
亚洲精品久久一区二区三区777
|
国产亚洲精久久久久久无码77777|
久久精品国产999大香线蕉|
一边摸一边做爽的视频17国产
|
国产欧美日韩视频在线观看|
久久久久久久久毛片|
国产麻豆视频一区|
国产99在线 | 亚洲|
日本免费在线视频不卡一不卡二|
av不卡中文字幕|
99国产精品视频免费观看一公开
|
国产视频一区二区三区在线观看|
久久久香蕉视频|
成人黄色综合网站|
男人操女人的视频网站|
国产白丝精品91爽爽久久|
中文字幕美女视频|
国产乱理伦片在线观看夜一区|
亚洲欧美va天堂人熟伦|
男人的天堂亚洲一区|
91精品国产自产|
日韩精品亚洲一区二区三区免费|
bl动漫在线观看|
亚欧成人精品|
欧美成人三级伦在线观看|
久久精品日产第一区二区
|
亚州色图欧美色图|
久久久久久国产免费|
三级毛片在线免费看|
97人洗澡人人免费公开视频碰碰碰|
久草在线新视觉|
欧美激情一二区|
日韩电影在线观看完整版|
97热精品视频官网|
wwwxxx在线观看|
国产精品久久久久久av|
av免费在线免费|
亚洲一区二区中文|
忘忧草在线影院两性视频|
精品国产日本|
国产激情欧美|
亚洲一区二区三区精品视频|
一区二区三区在线免费看|
第九区2中文字幕|
日本妇女一区|
乱子伦视频在线看|
亚洲欧美综合|
成人免费看片载|
奇米精品一区二区三区四区|
在线观看亚洲大片短视频|
国产电影一区二区三区|
久久综合激情网|
久久久99精品免费观看|
中文在线资源天堂|
午夜欧美2019年伦理|
亚洲最大最好的私人影剧院|
3atv在线一区二区三区|
日本网址在线观看|
在线性视频日韩欧美|
国产91久久久久蜜臀青青天草二
|
特级片在线观看|
国产无人区一区二区三区|
中日精品一色哟哟|
午夜精品福利视频网站|
884aa四虎免费影库4h|
亚洲成年人在线播放|
成人网18免费软件大全|
久久99久久99精品中文字幕|
国产日本在线|
亚洲精品日韩av|
欧美日韩亚洲国产|
色一情一乱一乱一区91|
欧美日韩高清|
国产sm在线观看|
久久超碰97中文字幕|
国产成人精品av久久|
亚洲色图制服丝袜|
天天综合天天综合|
欧美xxx久久|
成年人在线免费观看视频网站|
国内精品视频久久|
日本性爱视频在线观看|
日本免费一区二区三区|
日韩在线黄色|
五月天视频在线观看|
日本免费新一区视频|
免看一级a毛片一片成人不卡|
一区二区中文视频|
xxxxx69·hd|
亚洲娇小xxxx欧美娇小|
粉嫩欧美一区二区三区|
国产精品直播网红|
91超碰碰碰碰久久久久久综合|
成人国产一区二区三区|
中文字幕日韩欧美精品高清在线|
草草地址线路①屁屁影院成人|
不卡一区二区三区四区|
国产精品乱码久久久|
欧美人妖巨大在线|
成人网址大全|
欧美中文字幕在线播放|
第一福利在线视频|
日本三级中文字幕在线观看|
亚洲a一区二区三区|
久久久久久久久久久久久久久|
26uuu亚洲综合色|
精品人妻一区二区三区四区不卡
|
日韩欧美亚洲一二三区|
免费看大片爽|
韩国精品久久久999|
黄色18在线观看|
亚洲国产一二三精品无码|
亚洲网址在线|
www.毛片com|
亚洲综合成人在线|
羞羞网站在线观看|
久久免费视频网站|
自拍偷拍欧美视频|
青青草国产精品视频|
99精品国产在热久久|
久久久久性色av无码一区二区|
亚洲成人av福利|
人人在草线视频在线观看|
高清欧美性猛交|
丝袜美腿诱惑一区二区三区|
成熟了的熟妇毛茸茸|
日韩在线播放一区二区|
国产伦精品一区二区三区视频网站|
在线观看欧美精品|
黄色成人av|
亚洲伊人久久大香线蕉av|
久久a爱视频|
中文字幕人妻一区二区三区|
久久久久久日产精品|
中文先锋资源|
久久精品99国产精品酒店日本|
欧美家庭影院|
国产精品一色哟哟|
日韩av一二三|
少妇无套内谢久久久久|
日韩欧美国产一区二区在线播放|
超碰在线公开超碰在线|
国产福利久久精品|
国产精品密蕾丝视频下载|
日本激情小视频|
亚洲视频在线一区二区|
网站黄色在线观看|
欧美一级大片视频|
精品国产亚洲一区二区三区|
两女双腿交缠激烈磨豆腐|
26uuu亚洲综合色欧美|
四虎4hu影库永久地址|
欧美高清视频在线播放|
成人国产精品入口免费视频|
日本国产一级片|
91丨porny丨蝌蚪视频|
亚洲欧美精品中文第三|
欧美激情精品久久久|
精品久久久网|
91视频免费入口|
欧美国产日本视频|
一个人免费观看在线视频www|
热久久免费国产视频|
亚洲一区二区三区日本久久九|
亚洲熟女一区二区|
亚洲色图都市小说|
黑人巨大40厘米重口ysn|
91久久国产精品91久久性色|
亚洲精华一区二区三区|
三级黄色免费观看|
在线中文字幕不卡|
亚洲人成电影|
在线观看亚洲视频啊啊啊啊|
玖玖视频精品|
国产免费无遮挡|
中文字幕不卡av|
国产欧美一区二区三区精品酒店|
粉色视频免费看|
久久精品免视看|
桃乃木香奈和黑人aⅴ在线播放|
国产精品日韩电影|
国产欧美日韩|
久久久精品国产sm调教|
7777精品伊人久久久大香线蕉的
|
国产成人一区二区三区电影|
牛牛精品成人免费视频|
久久久久麻豆v国产|
欧美怡红院视频|
国产在线网站|
成人免费观看在线|
粉嫩在线一区二区三区视频|
亚洲成人国产综合|
国产成人av在线播放|
日韩理论电影中文字幕|
91免费国产精品|
精品写真视频在线观看|
亚洲图片小说网|
欧美一区二区三区免费观看|
午夜a一级毛片亚洲欧洲|
日韩成人毛片视频|
日韩一区二区在线看片|
91精品久久|
熟妇人妻无乱码中文字幕真矢织江|
久久色视频免费观看|
轻轻操 在线观看|
不卡一区二区三区视频|
亚洲网站啪啪|
国产99久一区二区三区a片|
久久99国产精品自在自在app
|
在线免费看黄色片|
五月天亚洲精品|
免费在线黄色影片|
日本国产在线播放|
久久免费美女视频|
jizz中国免费|
欧洲av一区|
久久成人精品无人区|
欧美四级剧情无删版影片|
国产精品国产三级国产aⅴ9色|
日韩精品免费一区二区在线观看|
男人午夜免费视频|
在线观看免费高清视频97|
日本电影久久久|
快灬快灬一下爽蜜桃在线观看|
欧美肥胖老妇做爰|
国产在线xxx|
激情小说欧美色图|
黑人巨大精品欧美一区二区|
超碰在线国产|
日韩肉感妇bbwbbwbbw|
亚洲精品成a人|
日本免费不卡|
可以免费观看av毛片|
136国产福利精品导航|
国产在线传媒|
免费看毛片的网址|
91免费国产视频网站|
免费看黄视频网站|
黄瓜视频免费观看在线观看www|
成人午夜激情视频|
h网站在线观看|
亚洲精品在线视频观看|
成人免费看视频|
先锋影音av资源网|
一区二区三区不卡在线|
caoporn国产精品|
97蝌蚪自拍自窝|
一级特黄妇女高潮|
久久精品视频网|
深夜爽爽视频|
欧美日韩黄色一级片|
亚洲少妇最新在线视频|
男女视频在线观看|
第四色婷婷基地|
激情亚洲一区二区三区四区|
91在线导航|
色姑娘综合天天|
欧美性大战久久久久久久|
sm性调教片在线观看|
成人免费无遮挡无码黄漫视频|
日韩视频中午一区|
成人精品国产亚洲|
久久久精品国产sm调教|
日韩在线观看免费高清完整版|
亚洲第一二三区|
亚洲在线观看av|
国产mv久久久|
亚洲最黄网站|
国产视频你懂的|
日韩三级电影|
99国产精品久|
欧美13~18sex性hd|